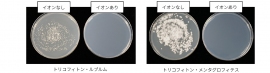
2種類の菌による効果試験の結果。(画像: シャープの発表資料より) 2種類の菌による効果試験の結果。(画像: シャープの発表資料より)

関連記事
シャープ、プラズマクラスターに水虫の抑制効果があることを実証
2種類の菌による効果試験の結果。(画像: シャープの発表資料より)[写真拡大]
シャープは22日、同社が開発した独自の空気浄化技術プラズマクラスターに、水虫の原因となる白癬菌を抑制する効果があることを実証した発表した。千葉大学真菌医学研究センターの協力で、白癬菌にプラズマクラスターを照射する実験を行ったところ、ほとんど生育が見られなかったという。
【こちらも】シャープ、日本人間工学会で最優秀賞を受賞したコードレス掃除機を発売
シャープによると、実験は国内で見られる水虫の90%以上の原因となっている2種類の白癬菌を使って行った。菌に24時間プラズマクラスターから発生するイオンを照射し、3~4日かけて菌を培養。イオンを照射しなかった菌と比較した。
すると、イオン照射しなかった菌は、コロニー(集落)と呼ばれる固まりを形成したが、照射した方はほとんどコロニーが検出されなかった。また、菌の状態を詳しく調べたところ、イオン照射した菌の「胞子」には発芽が見られず、発芽した後の「菌糸」もほとんど成長が見られなかったという。
さらに、イオン濃度と菌に対する抑制効果の関係について調べたところ、イオン濃度が高くなるほど、抑制効果が高くなることを確認した。
水虫はカビの一種である白癬菌が皮膚の角質層に感染して発症。長時間靴を履くなど、足が高温多湿の状態になると菌が増殖し、症状が現れる。浴室の脱衣所など、水虫患者が素足で触れる場所には必ず白癬菌が存在するといわれ、そこで家族に水虫をうつしてしまうことが多い。
この実験に参加した同センターの矢口貴史准教授は「プラズマクラスター技術には、白癬菌の胞子の発芽を抑制し、菌糸の成長も抑える効果があることが確認された。実際の家庭でも、水虫菌の繁殖を抑える可能性があると期待できる」としている。
プラズマクラスターは、プラスイオンとマイナスイオンを同時に空気中に放出し、化学反応によって細菌などの表面にあるタンパク質を分解、細菌などの働きを抑止するシャープ独自の空気浄化技術。同社の空気清浄機をはじめ、エアコンや冷蔵庫など多くの家電製品に搭載されている。
これまでも同社では、プラズマクラスターの効果を検証する実験を行い、新型インフルエンザウイルスや薬剤耐性細菌などの抑制効果を確認したという。
スポンサードリンク
